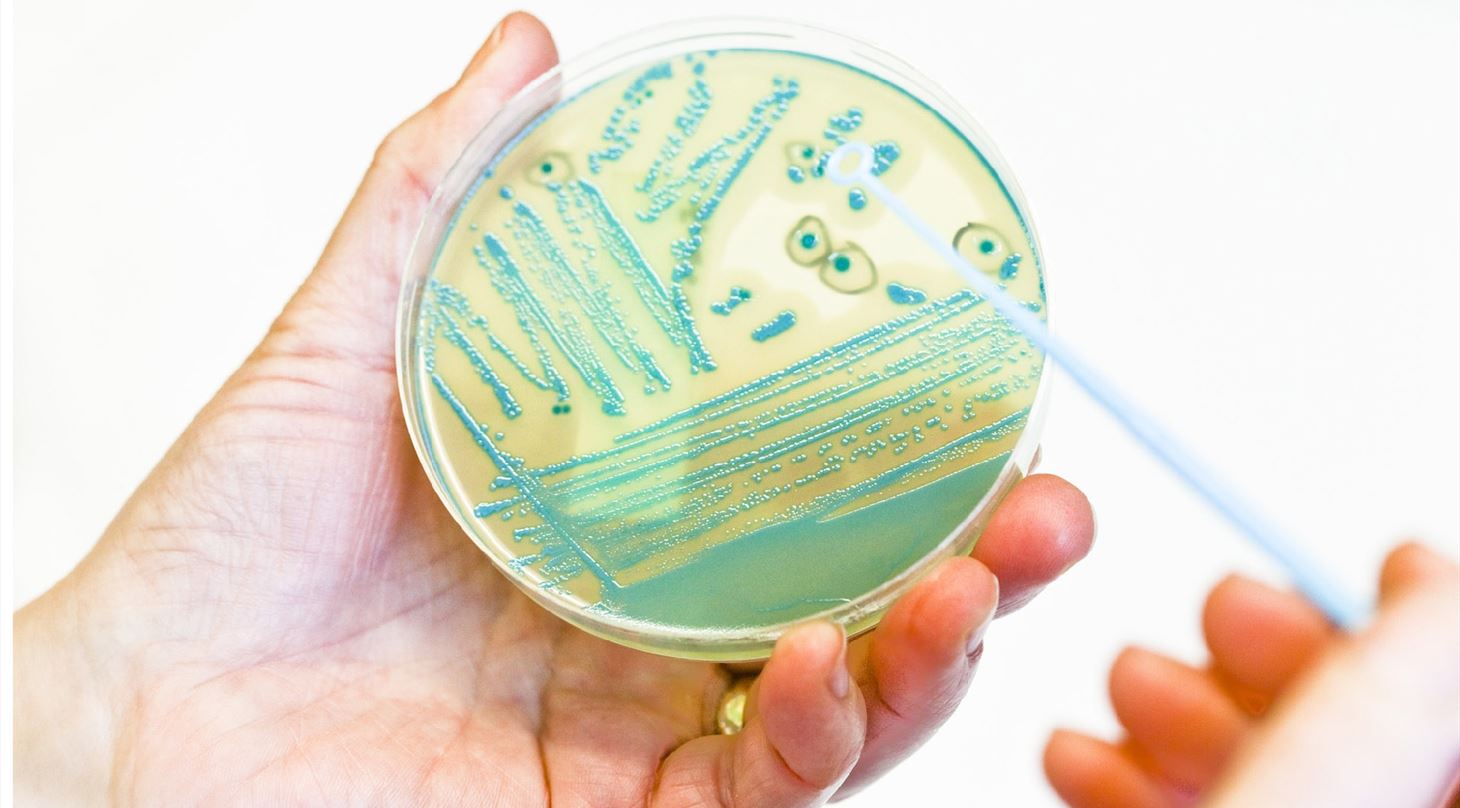

Bioburden af forskellige emner
I medicinal- og pharma-industrien er mikrobiel renhed af forskellige emner som mundbind og prøveudtagningsposer vigtig.
En bioburden test kan foretages på forskellige tidspunkter i produktionen af de givne emner som fx efter fremstilling og inden ibrugtagning, dette gælder bl.a. for mundbind. Her testes mundbindet for, om det er rent nok til brug.Â
Bioburden kan også være relevant at teste
- Før og efter vask af et emne (test: er den gennemførte vask fyldestgørende)
- Før og efter behandling (test: påfører den aktuelle behandling mikroorganismer)
Det mikrobiologiske laboratorium på Teknologisk Institut i Taastrup er akkrediteret af DANAK i henhold til DS/EN ISO/IEC 17025.